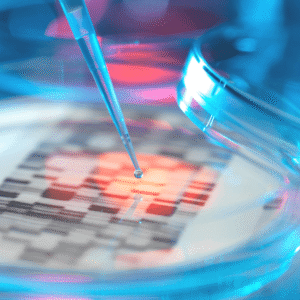

Pihtili, A., Galle, M., Cuhadaroglu, C., Kilicaslan, Z., Issever, H., Erkan, F., … & Gulbaran, Z. (2014). Evidence for the efficacy of a bioresonance method in smoking cessation: a pilot study. Forschende Komplementärmedizin/Research in Complementary Medicine, 21(4), 239-245.
Prospective randomized, controlled, double-blind clinical trial examining the efficacy of biofield therapy, using the MORA, in helping smokers quit. 190 participants were randomly assigned to bioresonance therapy (95) or simulated bioresonance therapy (95; placebo). Post-treatment, significantly fewer participants in the bioresonance group returned to smoking compared to participants in the placebo group. One year post-treatment, 28.6% of the bioresonance group remained smoke-free compared to 16.1% of the placebo group.